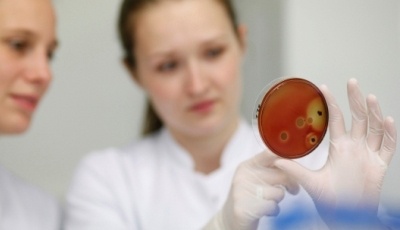
Im Rahmen des Forschungsprojektes (IGF-Nr. 16039 BG) haben Wissenschaftler...

Entwicklung einer leasingtauglichen, antimikrobiellen und komfortablen Arbeitskleidung
In vielen Bereichen, insbesondere in der Krankenhaus- und Altenheimpflege, aber auch in der Lebensmittelbetrieben und in der Gastronomie ist die Hygiene der Arbeitsbekleidung von hoher Bedeutung.
Im Rahmen des Forschungsprojektes (IGF-Nr. 16039 BG) haben Wissenschaftler der Hohenstein Institute in Kooperation mit dem Thüringischen Institut für Textil- und Kunststoff-Forschung und dem Sächsischen Textilforschungsinstitut an der Technischen Universität Chemnitz Gewebe für eine leasingtaugliche antimikrobielle Arbeitskleidung auf Basis von Celluloseregeneratfasern entwickelt und diese hinsichtlich ihrer Verarbeitung und Gebrauchseigenschaften untersucht.
Ziel des Forschungsprojektes war es, solche Eigenschaften wie Schutzfunktion, hohe mechanische Haltbarkeit, lange Lebensdauer und leichte Pflegbarkeit einerseits sowie gute physiologische Funktion der Kleidung und angenehmen Tragekomfort andererseits in einem Bekleidungsstück zu vereinen und eine reinweiße, antimikrobielle, leasingtaugliche und komfortable Arbeitskleidung aus Celluloseregeneratfasern herzustellen.
Textilien sind ein wesentlicher Übertragungsweg für Mikroorganismen und somit geht von unhygienischer Berufsbekleidung die Gefahr einer mikrobiellen Kontamination aus. Neben den hohen hygienischen Anforderung an die Arbeitskleidung ist der Tragekomfort und somit das Wohlbefinden des Trägers sehr wichtig. Nach wie vor wird Baumwolle von vielen Trägern aufgrund des guten Tragekomforts bevorzugt.
Celluloseregeneratfasern zeigen z. T. ähnliche Eigenschaften wie Baumwolle und lassen sich jedoch auf Grund ihrer synthetischen Herkunft antimikrobiell ausrüsten. Diese Eigenschaft wird bei der Herstellung des neuen Materials genutzt.
Häufig bezieht die auf dem Markt vorhandene antimikrobiell wirksame Arbeitskleidung ihre Wirkung aus Silber, welches in den Fasern verankert ist. Silber ist bereits seit ca. 3000 Jahren als Bakterizid bekannt. Ein Nachteil dabei ist, dass Silber je nach dem, in welcher Form es auf oder in die Faser gebracht wird, bei der Pflege oder unter anderen äußeren Einflüssen Farb- und Nachdunklungseffekte aufweist. Reinweiße Arbeitskleidung ist jedoch aufgrund der Assoziation mit Sauberkeit in hygienisch sensiblen Bereichen bevorzugt.
Bei der Entwicklung der neuen Materialien wurden zunächst drei Faser-Varianten hergestellt, bei der Zink, Zinkoxid und Silbernitrat zugesetzt wurden. Der Einsatz von Zink zur Erzeugung antimikrobieller Wirkung von Textilien ist ein innovativer Ansatz, da Zink bisher in Textilien kaum Verwendung fand. Zink zeichnet sich als Wirksubstanz durch die gleichen Vorzüge wie Silber aus und ist ein gesundheitlich unbedenklicher, gut untersuchter Wirkstoff, bei dem im Gegensatz zu Silber keine Verfärbungen bei der Verarbeitung und Pflege zu erwarten sind.
Die Ergebnisse zeigen, dass die neuen, gezielt dotierten Faservarianten, unter Berücksichtigung bestimmter Voraussetzungen, für die Herstellung von Arbeitskleidung mit einem hohem Anteil an cellulosischen Fasern möglich ist, was von den Trägern oft gewünscht wird. Bei der Variante mit Silbernitrat wurde zusätzlich Titanoxid zugegeben, um die spätere Verfärbung des Garns bereits im Herstellungsprozess zu vermeiden. Die Zugabe von Titanoxid führte bei der Faser mit Silbernitratbeladung zu keiner Verbesserung. Die auftretenden Verfärbungen wurden zwar aufgehellt, sind aber nach wie vor vorhanden.
Die Qualität der neuen Faservarianten wurde im Praxiseinsatz überprüft. Es wurden die textiltechnischen Mindestanforderungen wie Konfektionsvorgaben, Tragekomfort und Leasingtauglichkeit anhand der Vorgaben der DIN 10524 wie auch die antimikrobielle Wirksamkeit nach 100 Wasch- und Trocknungszyklen geprüft.
Die positiven Ergebnisse bestätigen, dass im Forschungsprojekt Grundlagen für eine neue, innovative Ausführung für antimikrobielle Textilien durch die Verwendung von Zink und cellulosischen Regeneratfasern geschaffen wurden. Diese neu entwickelte Faser sowie daraus erzeugtes Gewebe und Maschenware bieten einen wirksamen hygienischen Schutz, angenehmen Tragekomfort und eine hohe Leasingtauglichkeit und können somit zu einer verbesserten Hygiene wie auch zu einem Rückgang der besonders durch Lebensmittel übertragenen Infektionskrankheiten führen. Dadurch können die Infektionsraten der Bevölkerung wesentlich reduziert werden, was zu einer finanziellen Entlastung des Gesundheitssystems führt und so auch langfristig dem Beitragszahler zu Gute kommt.
Die Ergebnisse werden allen Interessierten, wie der Textilindustrie, der Chemischen Industrie und der Bekleidungsindustrie zur breiten Nutzung zur Verfügung gestellt.










